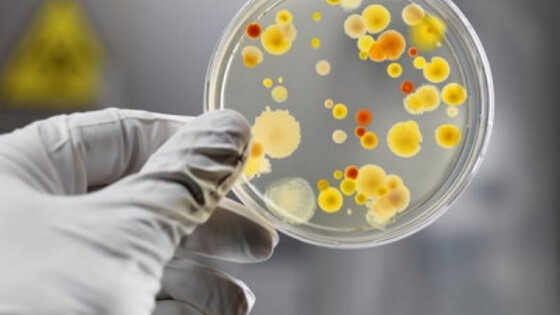

В Чувашии продолжаются противоэпидемические мероприятия в связи с выявлением случая брюшного тифа. Его выявили у жительницы Чебоксар, вернувшейся с отдыха из Таиланда. В связи с этим, решается вопрос о приостановлении работы кондитерской, в которой работала горожанка, также проводится дезинфекция по месту её жительства, сообщили ИА REGNUM в управлении Роспотребнадзора по Чувашии. Диагноз у пациентки был установлен 30 мая. Как ранее сообщало ИА REGNUM, накануне 25-летняя девушка вернулась из заграничного отдыха: свой отпуск она провела в Таиланде. Первые симптомы заболевания появились 22 мая (озноб, слабость, ломота в теле, температура). За медицинской помощью девушка она обратилась 26 мая в больницу скорой помощи и была госпитализирована в инфекционное отделение с первоначальным диагнозом ОРВИ. Через четыре дня выяснилось, что это брюшной тиф. Последний раз в республике это заболевание регистрировалось в 2000 году. По данному факту проводится санитарно-эпидемиологическое расследование, организованы противоэпидемические мероприятия. Проведена заключительная дезинфекция по месту работы и жительства заболевшей. Девушка является предпринимателем, работает в кондитерской. ИА REGNUM, в I квартале 2017 года в Чувашии из паразитарных и инфекционных заболеваний чаще всего регистрировались случаи ОРЗ (7097 случаев в расчёте на 100 тыс. населения), острые кишечные инфекции (228 случаев на 100 тыс. населения), ветряная оспа (314,5 случаев на 100 тыс. населения).